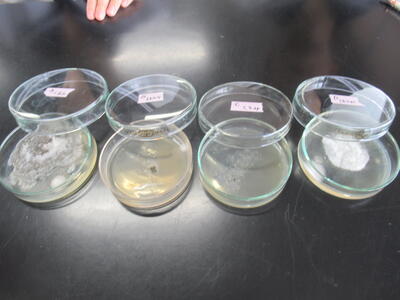

2023年7月の記事一覧
【本渡校舎】食品科学科3年生「手指の細菌検査②」
先週の微生物利用で使用した培地を培養し、観察を行いました。
左から 手洗いをしていない
② 手洗いのみ
③ 手洗い後アルコール消毒
④ 手洗い後アルコール消毒後顔や髪を触る
以上のように条件を変え、先週触れた培地を観察しました。
手洗い、消毒の大切さを実体験しました。
【本渡校舎】食品科学科3年生「ロールケーキ製造」
1学期最後の実習はロールケーキ製造を行いました。
体験入学では中学生にロールケーキのロールを予定しているので、予行練習もかねて行いました。
みんな上手に巻きました!!




中学3年生のみなさんお待ちしてまーす!!
【本渡校舎】食品科学科2年生「銀鏡反応」
2年生の食品化学は銀鏡反応を行いました。実験の様子をご覧下さい!!


【本渡校舎】食品科学科1年生「夏野菜の誘引」
野菜には梅雨も、暑さも関係なく、順調に成長しています!!
授業中に雨が降ってくることもありましたが、みんなで夏野菜の管理を行いました。

【本渡校舎】食品科学科1年生「編み込みパン製造」
パン製造3回目は、生地を三つ編み四つ編みを行う、編み込みパンの製造を行いました。
担当の先生の師範をみんな注目して見ています!!